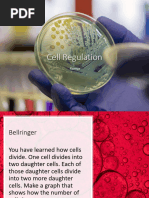

0% found this document useful (0 votes)
26 views6 pagesONS10 Se Ch01 Sec1 4 Page40to45
The document discusses the cell cycle, including interphase and cell division, and highlights the importance of cell cycle checkpoints that control cell growth and division. It explains how cancer can arise when cells ignore these checkpoints, leading to uncontrolled division and the formation of tumors. Additionally, it touches on the role of mutations in cancer development and emphasizes the need for cancer research and prevention strategies.
Uploaded by
Gera NandaCopyright
© © All Rights Reserved
We take content rights seriously. If you suspect this is your content, claim it here.
Available Formats
Download as PDF, TXT or read online on Scribd
0% found this document useful (0 votes)
26 views6 pagesONS10 Se Ch01 Sec1 4 Page40to45
The document discusses the cell cycle, including interphase and cell division, and highlights the importance of cell cycle checkpoints that control cell growth and division. It explains how cancer can arise when cells ignore these checkpoints, leading to uncontrolled division and the formation of tumors. Additionally, it touches on the role of mutations in cancer development and emphasizes the need for cancer research and prevention strategies.
Uploaded by
Gera NandaCopyright
© © All Rights Reserved
We take content rights seriously. If you suspect this is your content, claim it here.
Available Formats
Download as PDF, TXT or read online on Scribd
/ 6